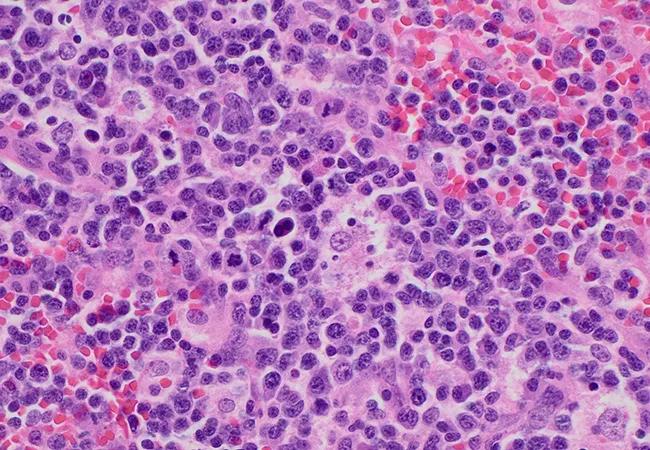

Claims data reveal disorder is often overlooked and undertreated
Image content: This image is available to view online.
View image online (https://assets.clevelandclinic.org/transform/efcd235c-fc28-42e2-8c1d-b07d1e28ca17/Mukherjee-CQD-654x450-1_jpg)
Mukherjee CQD 654×450
A new study examining the epidemiology of idiopathic multicentric Castleman disease (iMCD) estimates its prevalence in the United States to be approximately 2,200 cases. The estimate was derived from the application of claims-based algorithm to identify newly diagnosed cases of iMCD. The analysis – the largest of its kind – also revealed that fewer than 10% of patients with the disease receive treatment with an approved agent designed to target interleukin (IL-6).
Advertisement
Cleveland Clinic is a non-profit academic medical center. Advertising on our site helps support our mission. We do not endorse non-Cleveland Clinic products or services. Policy
These findings, published in Blood Advances, are more precise than those generated from prior epidemiologic studies, which identified iMCD based on rigorous criteria unavailable to previous investigators, explains Sudipto Mukherjee, MD, MPH, co-leader of the Rare Cancers and Blood Diseases program at Cleveland Clinic.
Before 2017, iMCD was identified by claims data using a nonspecific code that included all cases of lymphadenopathy. In the current study, investigators were able to search a U.S. administrative claims dataset of 30.7 million patients for cases using a Castleman disease-specific International Classification of Disease (ICD)-10 code. In addition, the unique claims-based algorithm incorporated the presence of corresponding diagnostic or laboratory claims that met two or more minor criteria, consistent with the published diagnostic criteria recommendations for iMCD. The algorithm also excluded patients with positive HHV-8 and HIV status.
“By creating a stringent case identification protocol based on these criteria, we were able to increase the diagnostic certainty of these cases identified through the claims code,” says Dr. Mukherjee. Of the 442 cases of Castleman disease that were identified, the algorithm confirmed 254 cases of iMCD.
“This data led to the realization that the disease burden of iMCD in the U.S. is higher than what we previously thought, which means that there are a lot of patients who could benefit from treatment if they are diagnosed properly in a timely manner,” he explains.
Advertisement
Currently, the IL-6-targeted monoclonal antibody siltuxumab is the only therapy approved for the treatment of iMCD by the U.S .Food and Drug Administration (FDA) and European Medicines Agency. The drug is recommended as a first-line therapy for the treatment of iMCD by both the National Comprehensive Care Network and the Castleman Disease Collaborative Network (CDCN).
Despite siltuximab’s approval by the FDA in 2014 and its status as the preferred therapy for iMCD in the aforementioned guidelines, it was prescribed for only 8.7% of patients with the disorder. Any IL-6-directed therapy was used in only 9.8%.
Corticosteroid monotherapy was the most commonly used treatment (39.0%). Remarkably, one-third of patients claimed receiving no treatment for their iMCD at all. Approximately 18% of patients underwent other treatments (namely immunomodulators, chemotherapy, or rituximab) but never received IL-6–targeted therapies.
The findings point to a huge unmet treatment need and the benefits of referral to an academic institution with expertise in the diagnosis of iMCD, explains Dr. Mukherjee.
“This treatment pattern is concerning because IMCD is not an indolent disease,” he says. “Our suspicion was that treatment is being held until patients are extremely sick, partly because a number of other medical conditions can mimic iCMD. That suspicion was confirmed when we discovered that patients who received IL-6-directed therapy had a higher number of minor criteria at the time of presentation compared with groups who received other treatments or no therapy at all.”
Advertisement
If treatment is not initiated in a timely manner, iCMD can adversely affect patients’ quality of life and can lead to complications down the road, including frequent hospitalizations and multiple emergency room visits, explains Dr. Mukherjee.
“Furthermore, many physicians may be unfamiliar with siltuximab, which is administered once every 3 weeks,” he notes.
The CDCN, which has identified centers of excellence for the management of iMCD and other subtypes of Castleman disease, maintains a directory of physicians with the necessary expertise.
“We are hopeful that these striking data will create awareness about the need to manage this vulnerable patient population with effective, time-sensitive therapies,” adds Dr. Mukherjee.
Advertisement
Advertisement
Research underscores the importance of access to timely diagnosis and treatment in this patient population.
A Cleveland Clinic model combining clinical staging, genomics and AI predicts survival with 18% greater accuracy — and could help match patients to more effective treatments.
Study serves as ‘cautionary tale’ for physicians tempted to rely on liquid biopsy results alone
Direct delivery of viral-based vector KB707 to the lungs may boost anti-tumor response and help overcome immune checkpoint inhibitor resistance
Evidence-based recommendations for managing pain, nausea and other treatment reactions
Emerging data and practice changes reduce toxicity burden of treatment
Understanding supports for adolescent and young adult patients
Reframing cancer survivorship